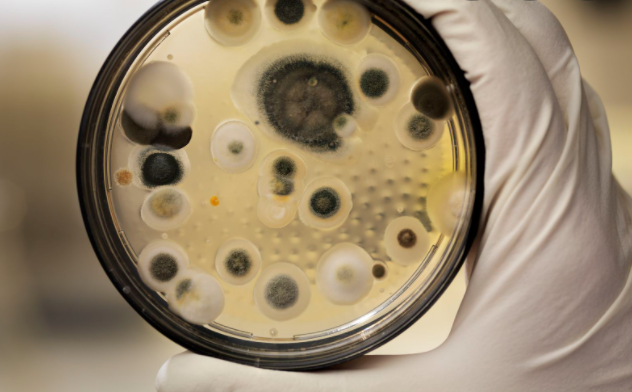
What's The Difference Between Mold & Mildew In San Diego?

What’s The Difference Between Mold & Mildew In San Diego?
Mold and mildew are often used interchangeably to describe unwanted growth in damp areas, but they are not the same thing. Professional mold remediation is necessary to identify your specific problem, resolve it before it becomes a serious problem, and fix any damage that has already occurred.
What Is Mildew?
Mildew is a fungus that grows on materials containing cellulose, such as wood or paper. The condition usually arises from the over-wetting of dry materials, leaving them exposed to excess moisture for an extended period of time. Mildew thrives on high humidity levels and temperatures above 70 degrees F . Once the area dries out, mildew will no longer grow— unlike most molds. This fungus commonly affects fabrics such as clothes, rugs, and upholstered furniture.
What Is Mold?
Mold is a microorganism that grows in mediums containing cellulose or other organic substances like food and paper. Mold often appears after flooding when water-damaged materials are exposed to excess humidity and moisture.
Temperatures don’t have to be high for mold growth; they can occur indoors at room temperature if the humidity level is high enough. Mold types vary depending on where they grow, but all are capable of causing allergic reactions in humans—especially when they grow indoors. Exposure to toxic mold may even cause serious health problems. The only way to avoid these harmful effects is by preventing mold from growing in the first place.
Mold reproduces rapidly and spreads quickly through your home or office, affecting areas much larger than their original location. In addition to being unsightly and potentially causing illness, mold can incur extensive damage to property.
When mold spores land on a damp surface in an enclosed area with little ventilation, they begin to grow into colonies—a process that could take less than 48 hours. So why is mold remediation so important? Because once you spot visible signs of growth, it’s already too late; the hidden dangers are already present throughout your structure.
Once detected, it must be removed immediately because time is a factor when dealing with mold; every 24 hours that goes by allows mold to spread, making the problem much harder to eradicate.
Conclusion
Unlike mildew, mold grows in dark areas and thrives on moisture. Professional mold remediation is usually necessary to identify your specific problem, resolve it before it becomes a serious problem, and fix any damage that has already occurred.
Call our experts of Smart Dry Restoration at (858) 433-5100 right away to get more information and mold and mildew removal in San Diego, CA.
Smart Dry Restoration
Address: 8910 Activity Rd Ste A San Diego CA 92126
Phone: (858) 433-5100
Check out our socials:
Facebook
Youtube
Instagram
Pinterest
Yelp